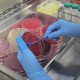

이번 공모는 지역 문화예술 활성화와 창작 활동 지원을 위해 2026년 한 해 동안 전시될 작품을 공개 모집해 무안예술 한켠 전시실을 지역의 다양한 창작인들이 자유롭게 참여할 수 있는 열린 전시 공간으로 만들고자 진행된다.
모집 작품으로는 미술, 사진, 공예, 디자인, 서예 등 다양한 작품을 신청할 수 있으며, 작품 주제에도 제한이 없어 평소 취미로 창작 활동을 이어온 주민들도 부담 없이 작품을 선보일 수 있다.
무안예술 한켠 전시실엔 9월부터 사진전, 서예·국화전에 이어 11월부터 진행 중인 공예·서양화전까지 관람객의 발길이 꾸준히 이어지고 있다.
한편, 신청 관련 내용은 무안군 홈페이지 공고를 통해 확인할 수 있으며, 추가 문의 사항이 있을 시, 무안군 문화예술과(☎ 061-450-4064)로 문의하면 된다.


 2025.12.05(금) 17:37
2025.12.05(금) 17:37